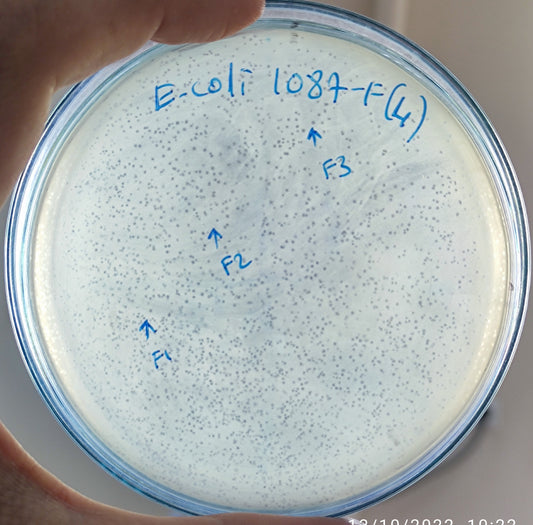
Escherichia coli bacteriophage 101087F
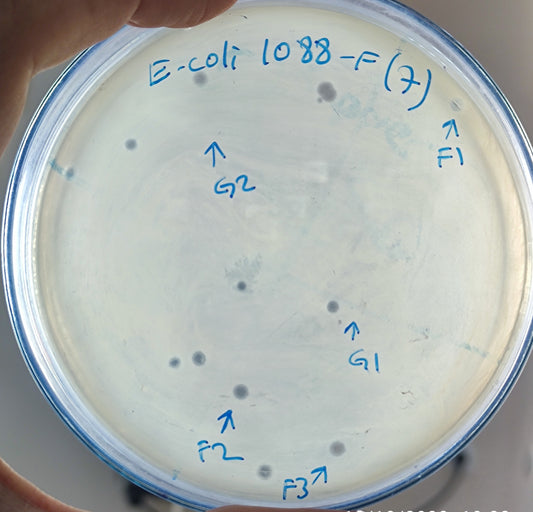
Escherichia coli bacteriophage 101088F
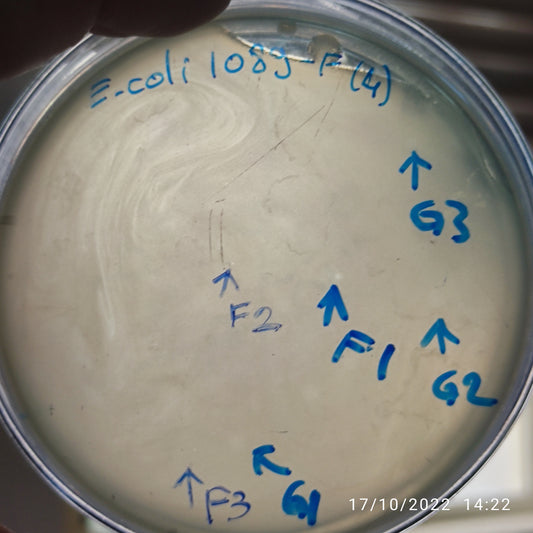
Escherichia coli bacteriophage 101089G
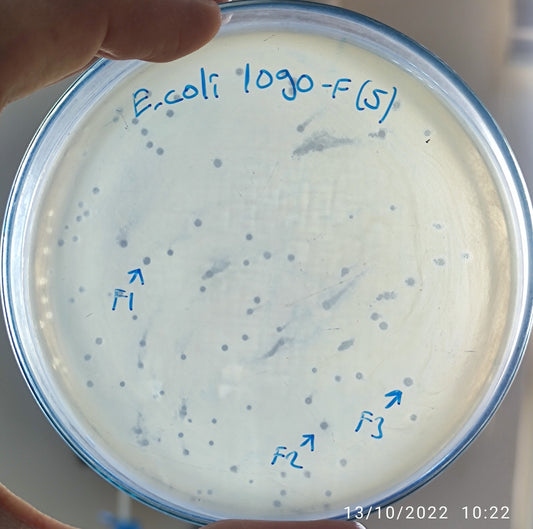
Escherichia coli bacteriophage 101090F
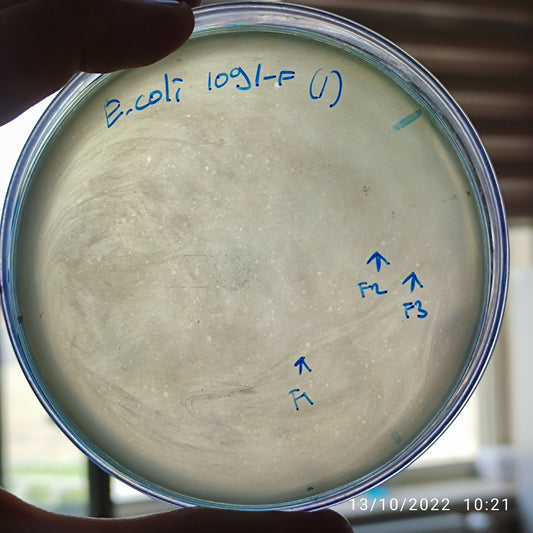
Escherichia coli bacteriophage 101091F
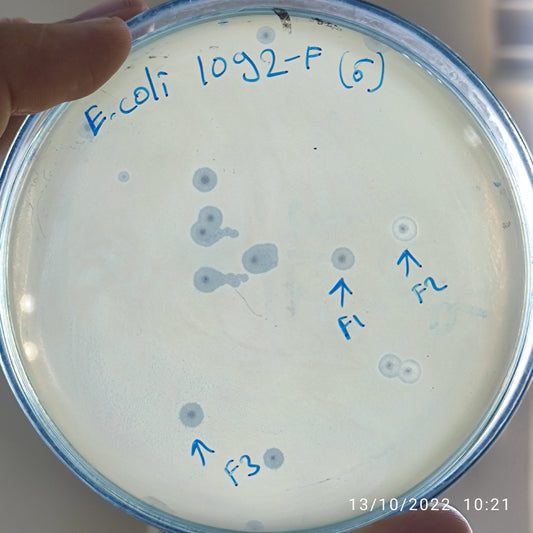
Escherichia coli bacteriophage 101092F
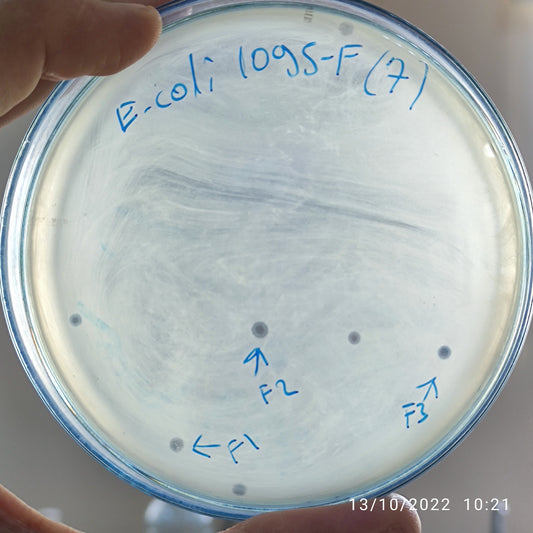
Escherichia coli bacteriophage 101095F
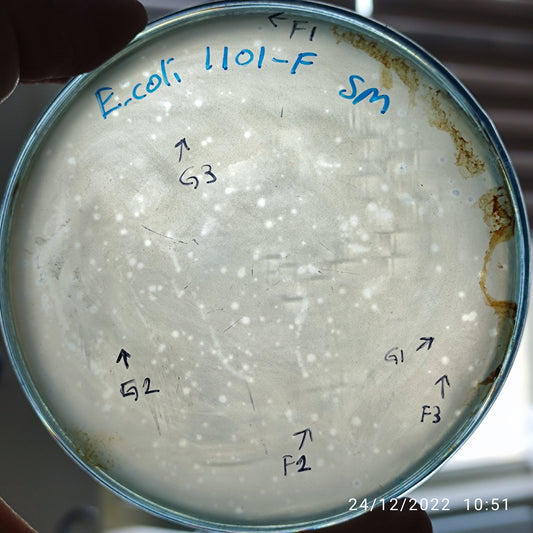
Escherichia coli bacteriophage 101101G
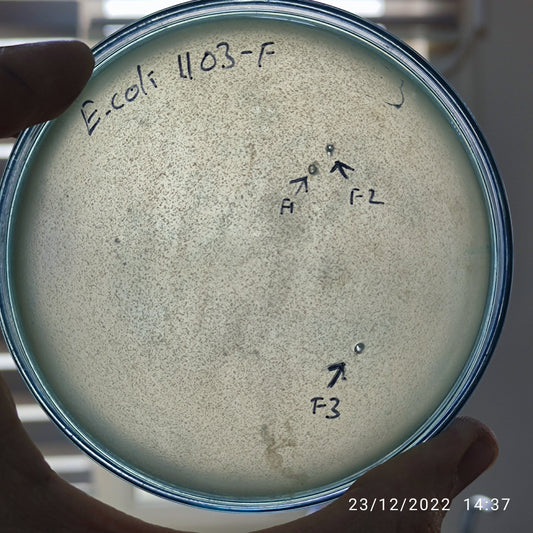
Escherichia coli bacteriophage 101103
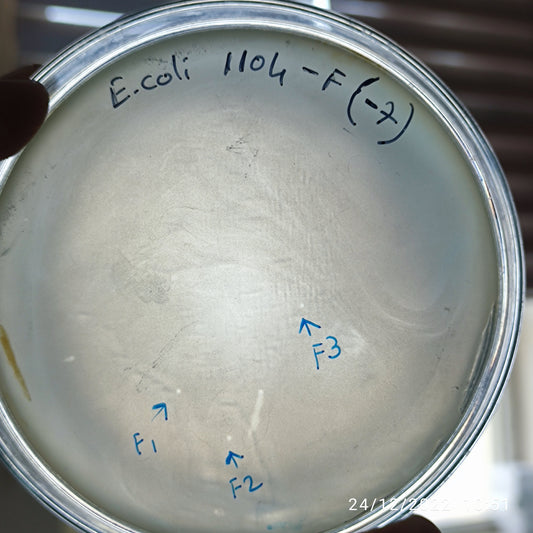
Escherichia coli bacteriophage 101104F

-
Escherichia coli bacteriophage 101085F
Regular price $500.00 USDRegular priceUnit price per -
Escherichia coli bacteriophage 101087F
Regular price $650.00 USDRegular priceUnit price per -
Escherichia coli bacteriophage 101088F
Regular price $800.00 USDRegular priceUnit price per -
Escherichia coli bacteriophage 101088G
Regular price $600.00 USDRegular priceUnit price per -
Escherichia coli bacteriophage 101089F
Regular price $500.00 USDRegular priceUnit price per -
Escherichia coli bacteriophage 101089G
Regular price $500.00 USDRegular priceUnit price per -
Escherichia coli bacteriophage 101090F
Regular price $800.00 USDRegular priceUnit price per -
Escherichia coli bacteriophage 101091F
Regular price $500.00 USDRegular priceUnit price per -
Escherichia coli bacteriophage 101092F
Regular price $900.00 USDRegular priceUnit price per -
Escherichia coli bacteriophage 101093F
Regular price $500.00 USDRegular priceUnit price per -
Escherichia coli bacteriophage 101093G
Regular price $500.00 USDRegular priceUnit price per -
Escherichia coli bacteriophage 101095F
Regular price $800.00 USDRegular priceUnit price per -
Escherichia coli bacteriophage 101101F
Regular price $500.00 USDRegular priceUnit price per -
Escherichia coli bacteriophage 101101G
Regular price $500.00 USDRegular priceUnit price per -
Escherichia coli bacteriophage 101103
Regular price $300.00 USDRegular priceUnit price per -
Escherichia coli bacteriophage 101104F
Regular price $500.00 USDRegular priceUnit price per